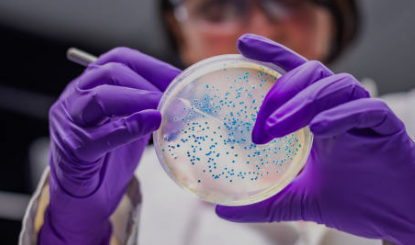

Schrijf je nu in {"blockElement":{"id":21056982,"pages_block_id":2827080,"uuid":"29f785dc-0a3c-480f-821d-f55629917b07","parent_id":21056981,"pages_block_element_type_id":20,"is_locked":false,"css_class":"element-29f785dc-0a3c-480f-821d-f55629917b07","position":8,"theme_style_type":"button_primary","tag":null,"blockElements":[],"blockElementType":{"id":20,"name":"Button","tree_icon":"fa-sharp fa-light fa-square-arrow-right","name_clean":"button","category":"element","default_content":"Call to action","allow_nested_elements":false},"styles":[{"id":1000000031324441,"uuid":"0bc0b448-dc2c-4acc-ac69-17813cfee15e","type":"button_primary","identifier":".element-29f785dc-0a3c-480f-821d-f55629917b07","target_device":"desktop","media_query":null,"classes":["inline-block","cursor-pointer","font-semibold","font-['Inter']","text-base","pt-[8px]","pb-[8px]","pl-[24px]","pr-[24px]","bg-[var(--primary-color)]","text-[#ffffff]","rounded-md","border-solid","border-[var(--primary-color)]","text-center","flex-1","border-[1px]","mr-[0px]"],"hover_classes":[],"keyed_classes":{},"animations":[],"css":null,"meta":null},{"id":1000000031324442,"uuid":"01b6b262-9973-4135-bffa-67022a1e8987","type":"button_primary","identifier":".element-29f785dc-0a3c-480f-821d-f55629917b07","target_device":"mobile","media_query":null,"classes":["mr-[0px]"],"hover_classes":[],"keyed_classes":{},"animations":[],"css":null,"meta":null}],"content":"<span class=\"button-span\"> Schrijf je nu in </span>","content_options":{"type":"checkout"},"form":null,"linkable":{"id":203304,"pages_block_element_id":21056982,"linkable_type":"App\\Models\\Checkout","linkable_id":346212,"params":null,"slug":"the-trail"},"images":[],"copied_from_block_element_id":199},"theme":{"id":517546,"uuid":"6afb03e9-5c34-41a7-8236-ca2b1c89c840","name":"Plug&Pay theme","is_global":false,"is_default":false,"text_font_size":"18px","text_font_size_mobile":"14px","text_font_family":"Roboto Condensed","text_font_color":"#000000","text_font_weight":"400","text_line_height":"1.5","text_line_height_mobile":"1.5","text_letter_spacing":"0","headings_1_font_size":"72px","headings_1_font_size_mobile":"36px","headings_1_font_family":"Roboto Condensed","headings_1_font_color":"#0F172A","headings_1_font_weight":"700","headings_1_line_height":"1.5","headings_1_line_height_mobile":"1.5","headings_1_letter_spacing":"0","headings_2_font_size":"48px","headings_2_font_size_mobile":"24px","headings_2_font_family":"Roboto Condensed","headings_2_font_color":"#0F172A","headings_2_font_weight":"600","headings_2_line_height":"1.5","headings_2_line_height_mobile":"1.5","headings_2_letter_spacing":"0","headings_3_font_size":"30px","headings_3_font_size_mobile":"20px","headings_3_font_family":"Roboto Condensed","headings_3_font_color":"#0F172A","headings_3_font_weight":"600","headings_3_line_height":"1.5","headings_3_line_height_mobile":"1.5","headings_3_letter_spacing":"0","headings_4_font_size":"18px","headings_4_font_size_mobile":"14px","headings_4_font_family":"Roboto Condensed","headings_4_font_color":"#0F172A","headings_4_font_weight":"400","headings_4_line_height":"1","headings_4_line_height_mobile":"1","headings_4_letter_spacing":"0","primary_color":"#3fa9f4ff","secondary_color":"#544b36ff","background_color":"#ecf5f9ff","max_width":"1170px","styles":[{"id":1000000031324373,"uuid":"3917c5a0-17a5-4215-93c9-c017a09bd08b","type":"button_primary","identifier":null,"target_device":"desktop","media_query":null,"classes":["inline-block","cursor-pointer","font-semibold","font-['Inter']","bg-[var(--primary-color)]","text-[#ffffff]","rounded-md","text-center","text-base","pt-[8px]","pb-[8px]","pl-[24px]","pr-[24px]","border-solid","border","border-[var(--primary-color)]","transition-all","duration-200","ease-in-out"],"hover_classes":["bg-[#bf1f1f]","border-[#bf1f1f]","scale-[1.06]"],"keyed_classes":{},"animations":[],"css":null,"meta":null},{"id":1000000031324374,"uuid":"d02c3c29-d13b-4ced-bfea-910211038fdb","type":"button_primary","identifier":null,"target_device":"mobile","media_query":null,"classes":[],"hover_classes":[],"keyed_classes":{},"animations":[],"css":null,"meta":null},{"id":1000000031324375,"uuid":"906637e2-0d67-4e2e-9ba4-673cd485c9c1","type":"button_secondary","identifier":null,"target_device":"desktop","media_query":null,"classes":["inline-block","cursor-pointer","font-semibold","font-['Inter']","bg-[var(--secondary-color)]","text-[#ffffff]","rounded-md","text-center","text-lg","pt-[12px]","pb-[12px]","pl-[40px]","pr-[40px]","border-none","shadow-material","transition-all","duration-200","ease-in-out"],"hover_classes":["bg-[#f7b305]","scale-[1.06]"],"keyed_classes":{},"animations":[],"css":null,"meta":null},{"id":1000000031324376,"uuid":"35975d8c-f3e3-4fc5-ac12-b6d204d10c06","type":"button_secondary","identifier":null,"target_device":"mobile","media_query":null,"classes":[],"hover_classes":[],"keyed_classes":{},"animations":[],"css":null,"meta":null},{"id":1000000031324377,"uuid":"77643614-b765-455d-8b35-906911f88283","type":"button_line","identifier":null,"target_device":"desktop","media_query":null,"classes":["inline-block","cursor-pointer","font-semibold","text-base","pt-[8px]","pb-[8px]","pl-[24px]","pr-[24px]","text-[var(--primary-color)]","rounded-md","text-center","font-['Inter']","shadow-none","bg-[#ffffff]","border-solid","border","border-[var(--primary-color)]","transition-all","duration-200","ease-in-out"],"hover_classes":["text-[#ffffff]","bg-[#dc2626]","border-[#ffffff]"],"keyed_classes":{},"animations":[],"css":null,"meta":null},{"id":1000000031324378,"uuid":"6056afe5-572e-4e19-92d2-0b63537f992e","type":"button_line","identifier":null,"target_device":"mobile","media_query":null,"classes":[],"hover_classes":[],"keyed_classes":{},"animations":[],"css":null,"meta":null},{"id":1000000031324379,"uuid":"a2faacbe-0dc6-4479-b2ae-5f7dcd32b59a","type":"button_transparent","identifier":null,"target_device":"desktop","media_query":null,"classes":["inline-block","cursor-pointer","font-semibold","font-['Inter']","text-base","pt-[8px]","pb-[8px]","pl-[24px]","pr-[24px]","bg-[#ffffff00]","text-[var(--secondary-color)]","rounded-none","border-none","text-center","border-0","border-[#ffffff00]","transition-all","duration-200","ease-in-out"],"hover_classes":["text-[#ffffff00]","bg-[#fbbf24]","border-[#ffffff00]"],"keyed_classes":{},"animations":[],"css":null,"meta":null},{"id":1000000031324380,"uuid":"12286dab-1b44-421a-bceb-0cafeca36e88","type":"button_transparent","identifier":null,"target_device":"mobile","media_query":null,"classes":[],"hover_classes":[],"keyed_classes":{},"animations":[],"css":null,"meta":null},{"id":1000000031324381,"uuid":"4fdd7f90-023b-40f7-b8e7-0239d3a6baf6","type":"card","identifier":null,"target_device":"desktop","media_query":null,"classes":["bg-[#ffffff]","border-none","shadow-none","p-10","rounded-xl"],"hover_classes":[],"keyed_classes":{},"animations":[],"css":null,"meta":null},{"id":1000000031324382,"uuid":"7f1c012f-7661-4a24-a2a3-aa834e6131c3","type":"card","identifier":null,"target_device":"mobile","media_query":null,"classes":[],"hover_classes":[],"keyed_classes":{},"animations":[],"css":null,"meta":null},{"id":1000000031324383,"uuid":"f4857153-1e32-492a-b2a4-f165a9093ad9","type":"shadow","identifier":null,"target_device":"desktop","media_query":null,"classes":["shadow-material"],"hover_classes":[],"keyed_classes":{},"animations":[],"css":null,"meta":null},{"id":1000000031324384,"uuid":"1451b067-8e32-4afc-9625-9be003e58a95","type":"shadow","identifier":null,"target_device":"mobile","media_query":null,"classes":[],"hover_classes":[],"keyed_classes":{},"animations":[],"css":null,"meta":null},{"id":1000000031324385,"uuid":"e5e3375e-3f85-460f-984b-c641c3f9a52c","type":"corner","identifier":null,"target_device":"desktop","media_query":null,"classes":["rounded-md"],"hover_classes":[],"keyed_classes":{},"animations":[],"css":null,"meta":null},{"id":1000000031324386,"uuid":"d164908b-d9e9-488a-8334-2a38d1574a7a","type":"corner","identifier":null,"target_device":"mobile","media_query":null,"classes":[],"hover_classes":[],"keyed_classes":{},"animations":[],"css":null,"meta":null},{"id":1000000031324387,"uuid":"4ef80143-0c2c-4bc9-957f-c7bb21efb6f7","type":"image","identifier":null,"target_device":"desktop","media_query":null,"classes":["rounded-md","shadow-material"],"hover_classes":[],"keyed_classes":{},"animations":[],"css":null,"meta":null},{"id":1000000031324388,"uuid":"5dc1a800-a85d-4b6f-b6a5-ef5cd2b93450","type":"image","identifier":null,"target_device":"mobile","media_query":null,"classes":[],"hover_classes":[],"keyed_classes":{},"animations":[],"css":null,"meta":null}]}}